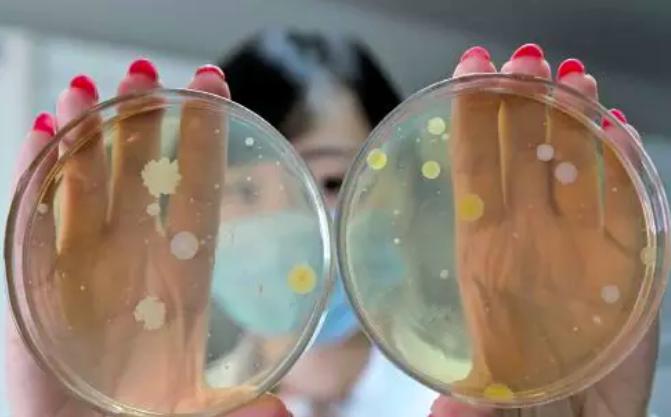
网红宣传化妆品骗局,网红卖的化妆品骗局是真的吗

估计很多女生都被李佳琦种草过,众多口红、粉底液等多种化妆品都被他宣传的超级具有吸引力
而这也成为一种独特的销售模式,带动了一众网红产业

国外也有很多美妆博主,不过也有美妆博主更会另辟蹊径寻找一些不同的道路
例如这个小姐姐,她的日常就是告诉大家如何来节省垃圾的浪费

据说她连续四年是产生了大概一小袋子的垃圾,其他的很多东西都会被回收利用

其中她最厉害的就是自己diy牙膏、香皂、洗发水等物品
因为她觉得购买现成产品会造成很多的塑料垃圾

她会从网上查关于手工皂的制作方法,然后自己亲手制作一个

甚至睫毛膏没有了,也会考虑如何自己打造一个专属的睫毛膏产品

就拿牙膏来说,把3勺椰子油、1勺半小苏打粉,和20滴食用薄荷精油混合搅拌在一起

一个简单便捷的牙膏产品就这样产生了,每周这个姑娘都会花一个小时的时间来diy自己的所需品

这样子的操作确实让她节约了不少成本也吸引了很多人的目光,同时也引发了一大批效仿的热潮

甚至有不少网红觉得diy护肤品过于简单,开始打起来diy化妆品的主意
所有的制作资料都是从网络上学习来的,然后就敢放话可以媲美YSL

而且这股风气也越来越盛行,甚至开始鼓吹所有化妆品都能够在家制作

有些在家里diy粉底液,甚至按照克数精准测量

制作口红的则比较麻烦,将红色可食用燃料重新融化

然后将其灌入到模具中

配合特殊道具,将口红取出来

最后开盖即可,每每他们宣扬这样的diy制作方法绝对安全
跟大牌的效果是一样的,可能的确出来的色号是相同的,但是绝对安全可不一定吧

不少网友也对这件事情表示不可理解,如此制作口红跟三无产品有何区别

更有网友说按照方法diy了粉底液,却发现没多久脸上就开始过敏了!

面部肌肤是很脆弱的存在,都没有质量检测过的产品,你轻易就上脸,真的是胆子太大了
因为在家的环境里,会蕴藏很多不可见的细菌,这些细菌的滋生会对于肌肤产生很多的影响

而正规的化妆品与护肤品都有专门的无菌环境,会避免细菌的滋生
当你觉得diy化妆品绝对安全的话,按你们之间的差距可能就是在于如何避免细菌上

所以不要觉得diy化妆品很靠谱,为了自己的安全,还是购买正规产品吧!